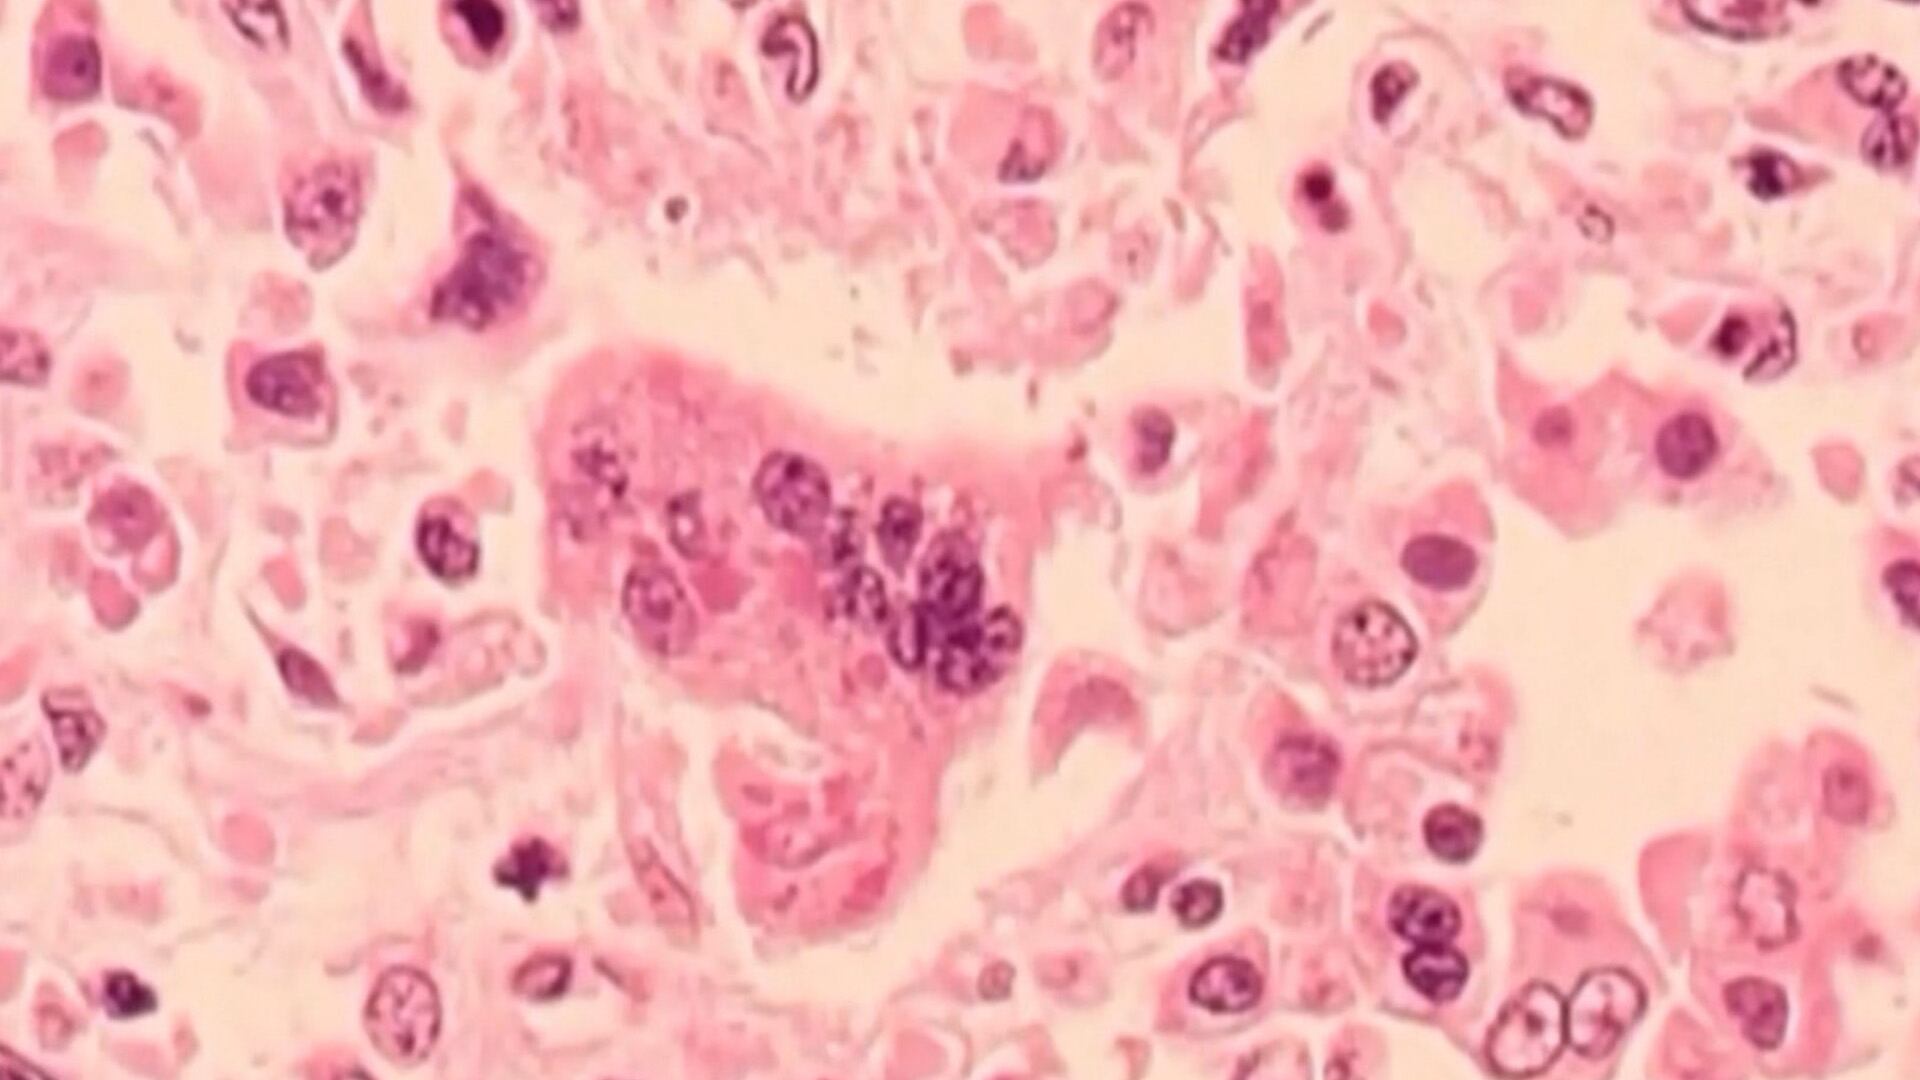

Un nourrisson du sud-ouest de l'Ontario qui avait contracté la rougeole de sa mère avant la naissance et qui était né prématurément est décédé, a déclaré le médecin hygiéniste en chef de l'Ontario.
La mère de l'enfant n'avait pas été vaccinée contre cette maladie virale, a déclaré le Dr Kieran Moore dans son communiqué.
Si la rougeole peut être mortelle, en particulier pour les jeunes enfants, le Dr Moore a souligné que l'enfant avait également été confronté à d'autres «complications médicales graves».
Ce texte est une traduction d’un article de CTV News
Par respect pour la famille, aucun autre détail médical n'a été communiqué concernant la mère et le bébé, précise-t-on.
«Je présente mes sincères condoléances à la famille en cette période incroyablement difficile», a indiqué le Dr Moore. «Je tiens également à remercier les professionnels de santé dévoués qui se sont occupés de la mère et de l'enfant avec compassion et compétence.»
L'Ontario est aux prises avec une épidémie de rougeole depuis octobre, les premiers cas étant liés à une épidémie qui a débuté au Nouveau-Brunswick.
De nouvelles données publiées par la province jeudi montrent que l'Ontario a enregistré 2009 cas lors de la dernière épidémie, la grande majorité de ces cas étant regroupés dans plusieurs unités de santé du sud-ouest de l'Ontario. Selon les chiffres de la province, ces chiffres sont nettement inférieurs à ceux de la dernière décennie, au cours de laquelle l'Ontario a rarement enregistré plus de 20 cas par an.
Les autorités sanitaires ont déclaré que la grande majorité des cas se produisent chez des personnes non vaccinées. Un vaccin efficace contre le virus existe depuis plus de 50 ans et fait généralement partie des vaccinations de routine des enfants.
«La rougeole présente un risque grave pour les personnes non vaccinées et, en particulier, pour les nourrissons en début de vie. La rougeole est l'une des maladies les plus contagieuses et peut entraîner de graves complications, notamment une pneumonie, un gonflement du cerveau, une naissance prématurée et, dans de rares cas, la mort», a déclaré M. Moore.
«Toute personne non vaccinée court un risque et j'invite instamment tout le monde, et en particulier les femmes susceptibles d'être enceintes, à s'assurer qu'elles ont reçu deux doses du vaccin ROR, qui protègera à la fois les parents et le bébé.
Les bébés reçoivent normalement leur première dose de vaccin à l'âge de 12 mois, mais les habitants des régions de la province touchées par l'épidémie se voient proposer une injection dès l'âge de six mois.
La rougeole est un virus respiratoire très contagieux qui se propage dans l'air. Il peut également être transmis en se touchant les yeux, le nez ou la bouche après avoir touché une surface infectée, selon Santé publique Ontario. Les symptômes comprennent la fièvre, la toux, l'écoulement nasal, les yeux rouges et larmoyants et une éruption cutanée rouge.
La province a réagi à l'épidémie en menant une campagne d'éducation publique ciblée sur la rougeole et en mettant l'accent sur la vaccination des enfants dans les zones touchées.